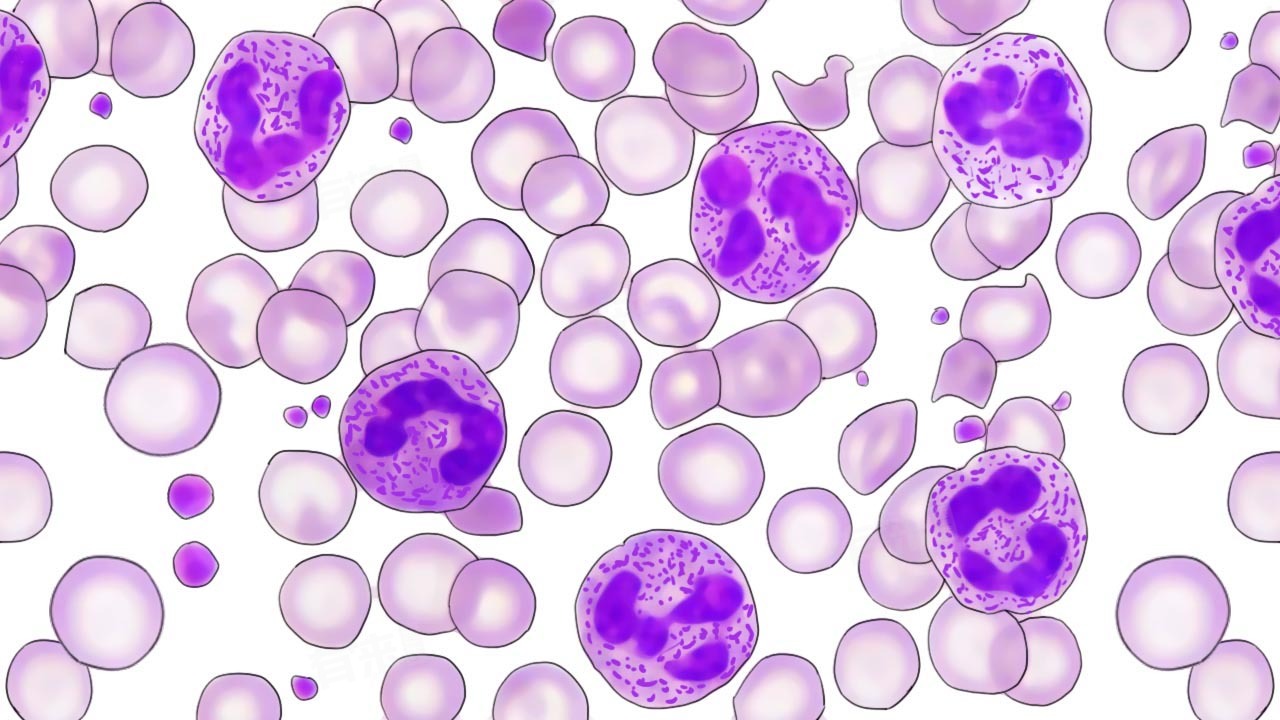

中性粒细胞数偏高可能是生理性因素引起,也可能提示身体存在某些疾病,如急性感染、严重组织损伤、急性大出血或恶性肿瘤等,必要时应及时就医,进行进一步的检查和诊断,以便采取相应的治疗措施。
1、生理性因素:在一些生理情况下,中性粒细胞数量可能会暂时升高,如在剧烈运动、饱餐、淋浴后或妊娠后期,人体的新陈代谢加快,血液循环加速,可导致中性粒细胞数轻度偏高。这种生理性升高通常是暂时的,身体恢复平静后,中性粒细胞数会逐渐恢复正常。
2、急性感染:当身体某个部位发生急性感染时,如肺炎、扁桃体炎、胆囊炎等,免疫系统会迅速做出反应,动员中性粒细胞前往感染部位吞噬病原体。血液中的中性粒细胞数量会明显增加。除了中性粒细胞数偏高外,患者通常还会伴有发热、疼痛、红肿等感染症状。
3、严重的组织损伤:如急性心肌梗死、大面积烧伤、严重外伤等,中性粒细胞会大量释放到血液中,以应对组织损伤引起的炎症反应,中性粒细胞数的升高往往是机体的一种应激反应。
4、急性大出血:在急性大出血时,身体会出现应激性的骨髓造血反应,导致中性粒细胞大量释放到外周血中,如消化道大出血、咯血等情况,都可能引起中性粒细胞数偏高。大出血还可能导致贫血、休克等严重后果,患者会出现面色苍白、头晕、乏力等症状。
5、恶性肿瘤:如肺癌、胃癌、肝癌等,可释放一些物质刺激骨髓造血,导致中性粒细胞生成增加,肿瘤组织的坏死和炎症反应也会吸引中性粒细胞聚集。中性粒细胞数偏高可能是恶性肿瘤的一个伴随症状,但通常不是特异性的诊断指标,患者还可能出现消瘦、乏力、疼痛等肿瘤相关症状。
当中性粒细胞数偏高时,不要盲目恐慌,但也不能忽视。患者要注意观察自身症状的变化,如体温、疼痛程度、出血情况等,如果正在服用某些药物,应告知医生,因为某些药物可能会影响中性粒细胞的数量。
中性粒细胞数偏高的注意要点
- 如果发现中性粒细胞数偏高,但其他检查结果正常,且身体没有明显不适症状,建议定期复查血常规。一般可以在1-2周后复查,观察中性粒细胞数的变化情况,如果中性粒细胞数持续升高或出现其他异常变化,应进一步检查明确原因。
- 密切关注自身是否出现新的症状或原有症状的加重,如是否有发热、咳嗽、咳痰、腹痛、腹泻、皮肤红肿等症状,任何异常症状都可能是身体发出的信号,提示存在潜在的健康问题。
- 患者需要保证充足的睡眠,避免熬夜,有助于提高身体的免疫力。合理饮食,多摄入富含维生素、矿物质和蛋白质的食物,如新鲜蔬菜、水果、瘦肉、鱼类等,要适量运动,增强体质,但避免过度劳累。
- 如果医生建议进一步进行其他检查,如骨髓穿刺、血培养、肿瘤标志物检测等,应积极配合。这些检查有助于明确中性粒细胞数偏高的原因,从而制定针对性的治疗方案,不要因为害怕检查或担心费用而拒绝检查,以免延误病情。

